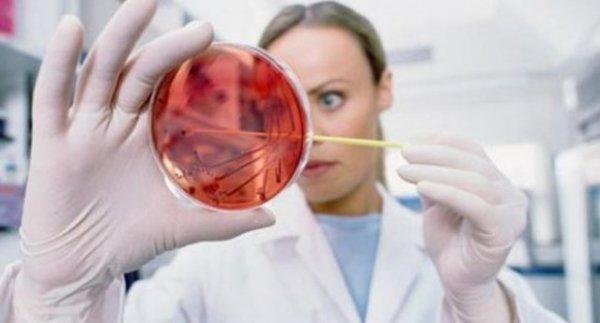
Türkiye'de 3,5 milyon kişi hepatit B taşıyıcısı

Dünya çapında 325 milyon kişinin hayatını etkileyen hepatit B ve C'nin, her yıl 1.4 milyon kişinin ölümüne yol açtığı belirtildi.
Abdi İbrahim Medikal Direktörlüğü'nden 28 Temmuz Dünya Hepatit Günü kapsamında yapılan açıklamada, kronik karaciğer hastalığı, siroz ve karaciğer kanserine yol açabilen hepatitlerin, tüm dünyada yaygın olarak görülen ve ülke ekonomisini yakından ilgilendiren bir hastalık olduğuna dikkati çekilen açılamada, viral hepatitlerin, karaciğer kanserinin temel nedeni ve tüberkülozdan sonra ikinci majör ölümcül bulaşıcı hastalık olduğu kaydedildi.

Viral hepatitlere A, B, C, D, E gibi farklı virüs tiplerinin sebep olduğu anlatılan açıklamada, şu bilgilere yer verildi:
"Türkiye, hepatit B virüsü görülme sıklığı açısından orta düzeydeki ülkeler arasında yer alıyor. Türk Karaciğer Araştırmaları Derneği'nin 2009-2010 yılları arasında yaptığı çalışmanın sonuçlarına göre, Türkiye nüfusunun yaklaşık 1/3'ünün hepatit B virüsü ile karşılaştığı ve yaklaşık 3,5 milyon kişinin hepatit B virüsünü yenemeyerek virüs ile infekte olduğu tahmin ediliyor.
Kan ve diğer vücut sıvıları yoluyla bulaşan virüs; hepatit B virüsü taşıyan kişi ile korunmasız cinsel ilişkiye girilmesi, tıraş bıçağı, tırnak makası gibi özel eşyaların paylaşılması, damar içi ilaç bağımlısı olanlarda ortak enjektör kullanılması, steril olmayan şartlarda cerrahi işlem, dövme yapılması sonucunda veya doğum esnasında anneden bebeğe geçebiliyor."
"HEPATİT B, HİÇBİR BELİRTİ GÖSTERMEYEBİLİR"
Açıklamada, kanında hepatit B virüsü bulunan bireylerin çoğunda hastalığa ait belirtilerin olmaması, hastalığın uzun süre teşhisinin konulamamasına ve tedavisiz kalmasına yol açtığı belirtilerek, şunlar kaydedildi:
"Hepatit B hastalarının sadece yüzde 11'i hepatit B virüsü taşıdığının farkında. Oysa hepatit önlenebilir ve tedavi edilebilir bir hastalık. Bu nedenle hepatit ile mücadelede aşı gibi koruyucu önlemlerin alınması, risk gruplarının taranarak belirlenmesi, değişik toplum katmanlarında ve sağlık çalışanlarında farkındalığın artırılarak hastalığın erken tespiti ve uygun tedavi ile takibinin sağlanması büyük önem taşıyor.
Dünya Sağlık Örgütü'nün 2030 yılında hepatiti elimine etme hedefleri doğrultusunda Sağlık Bakanlığı, 'Türkiye Viral Hepatit Önleme ve Kontrol Programı'nı (2018-2023) hazırladı. Program ile viral hepatit yeni vaka sayısı ve viral hepatitlere bağlı ölümlerin azaltılması, viral hepatit tanısı alan hastaların bakımının iyileştirilmesi ve viral hepatitlerin toplumsal alanlarda oluşturduğu sosyoekonomik etkinin azaltılması amaçlanıyor.



